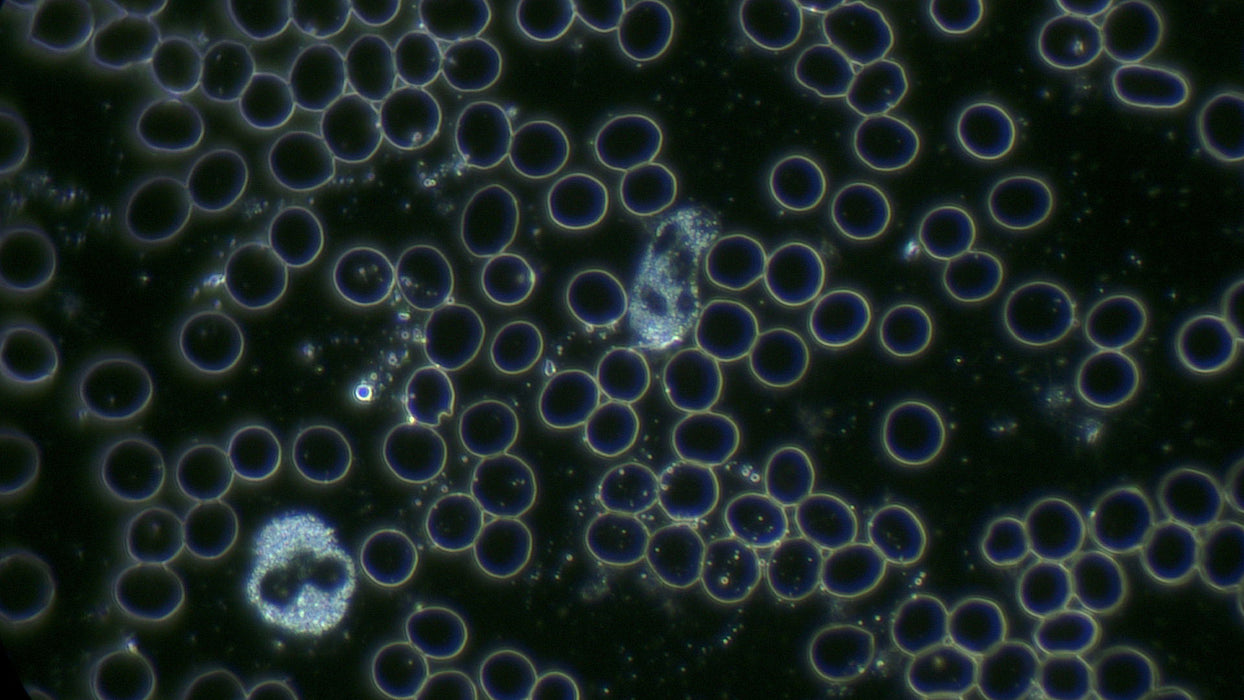
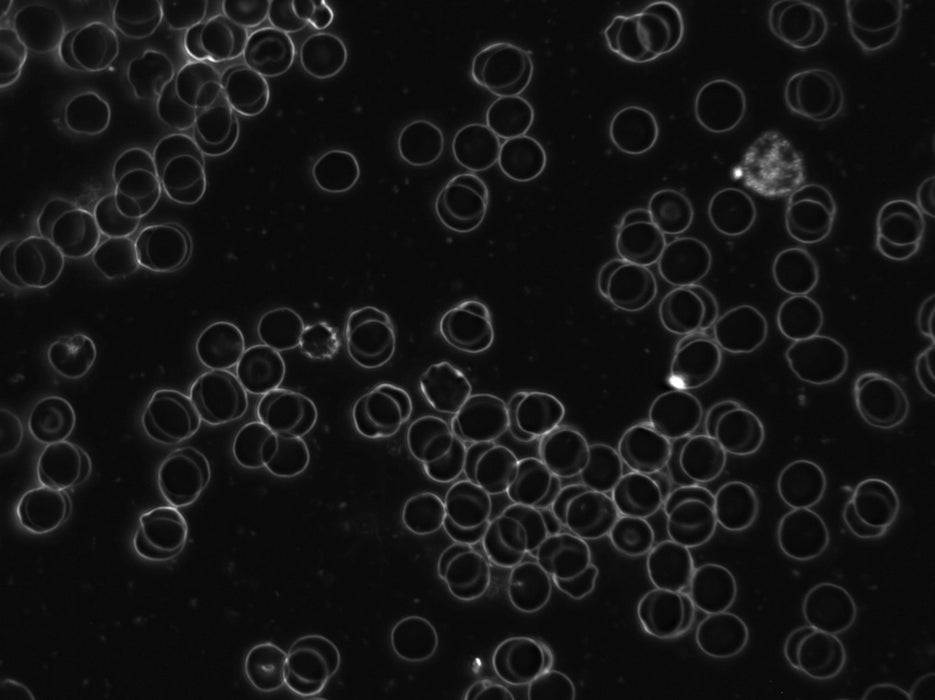
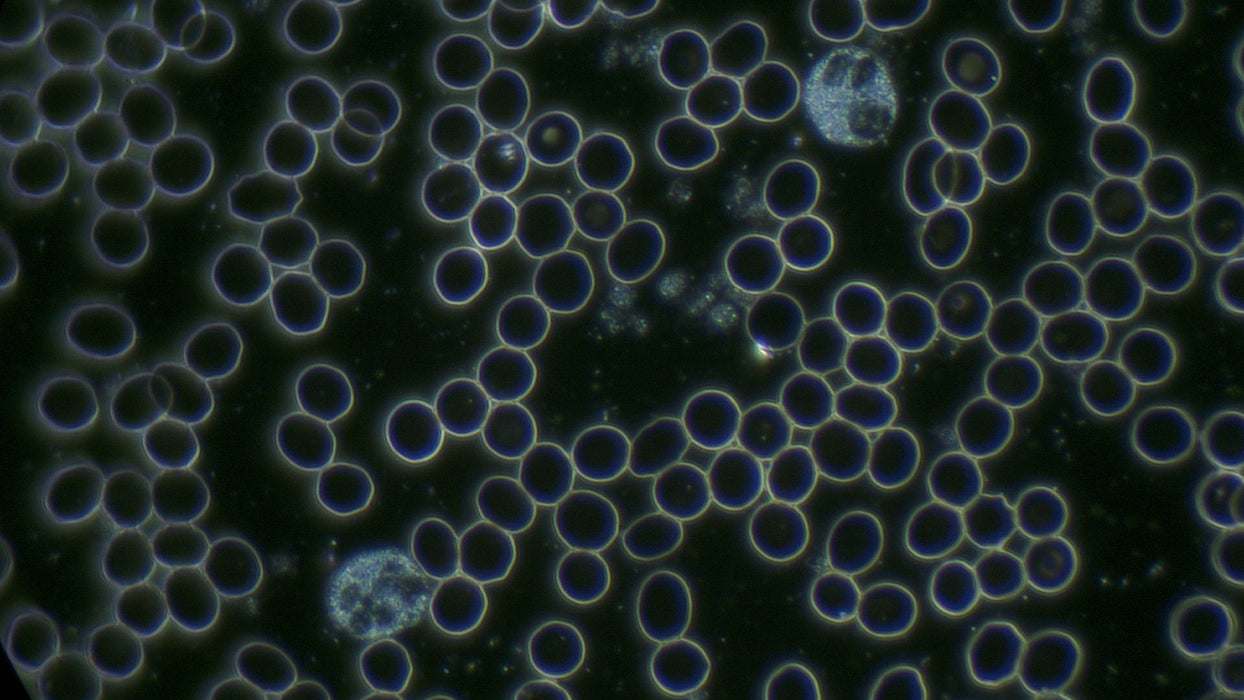

100X OIL IMMERSION DARKFIELD OBJECTIVE
by Optico
Original price
$675.00
-
Original price
$675.00
Original price
$675.00
$675.00
-
$675.00
Current price
$675.00
100x Oil Immersion Darkfield Objective with Iris Diaphragm
Infinity-Corrected PLAN Achromatic microscope objective lens with integrated iris diaphragm for ultra dark field microscopy.
Fits common size (DIN/JIS international standard) Compound Biological Microscopes.